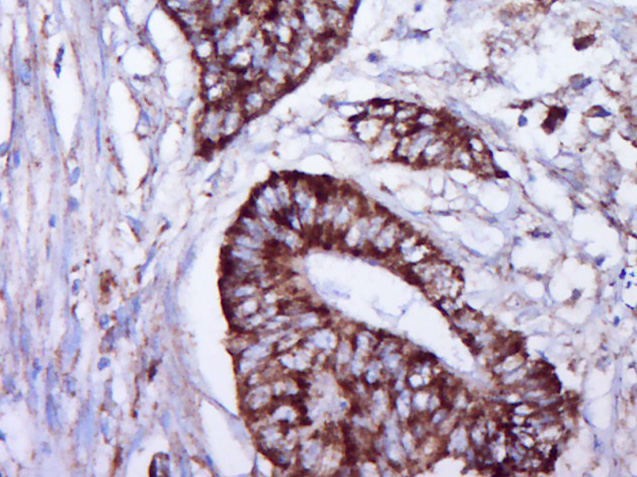
产品细节图片1

相关产品推荐更多 >

PRSS42 Rabbit pAb(bs-19442R)-50ul/100ul/200ul
¥1180
C2orf16 Rabbit pAb(bs-15147R)-50ul/100ul/200ul
¥1180
hTau40 Mouse mAb(bsm-41722M)-100ul/50ul/200ul/200ug
¥1180
phospho-NFKB1 (Ser373) Rabbit pAb, PerCP-Cy7 conjugated(bs-20075R-PerCP-Cy7)-100ul
¥2980
ZNF385B Rabbit pAb, PE-Cy5.5 conjugated(bs-12809R-PE-Cy5.5)-100ul
¥2980
万千商家帮你免费找货
0 人在求购买到急需产品
- 详细信息
- 文献和实验
- 技术资料
- 应用范围:
产品信息以Bioss网站为准
- 规格:
50ul/100ul/200ul
| 规格: | 50ul | 产品价格: | ¥1180.0 |
|---|---|---|---|
| 规格: | 100ul | 产品价格: | ¥1980.0 |
| 规格: | 200ul | 产品价格: | ¥2800.0 |
| 产品编号 | bs-5304R |
| 英文名称 | phospho-Separase (Ser1073) Rabbit pAb |
| 中文名称 | 磷酸化外纺锤体极样蛋白1抗体 |
| 英文别名 | Caspase like protein ESPL1; ESP 1; ESP1; ESP-1; ESPL 1; ESPL1; ESPL-1; Extra spindle poles like 1; Extra spindle poles like 1 protein; Separin; Similar to fission yeast cut1and gene; SSE; Separase; ESPL1_HUMAN. |
| 产品应用 | IHC-P=1:100-500, IHC-F=1:100-500, IF=1:100-500 Not yet tested in other applications. |
| 交叉反应 | Human |
| 抗体来源 | Rabbit |
| 免疫原 | KLH conjugated Synthesised phosphopeptide derived from human ESPL1 around the phosphorylation site of Ser1073 |
| 亚型 | IgG |
| 性状 | Liquid |
| 纯化方法 | affinity purified by Protein A |
| 克隆类型 | Polyclonal |
| 理论分子量 | 198 kDa |
| 浓度 | 1mg/ml |
| 储存液 | 0.01M TBS (pH7.4) with 1% BSA, 0.02% Proclin300 and 50% Glycerol. |
| 研究领域 | Cell Biology > Cell Cycle > Cell Division > Chromatid Cohesion Epigenetics and Nuclear Signaling > Cell cycle > Chromosome Structure > Chromatid Cohesion |
| 亚基 | Interacts with PTTG1. Interacts with RAD21. |
| 亚细胞定位 | Cytoplasmic and Nuclear |
| 翻译后修饰 | Autocleaves. This function, which is not essential for its protease activity, is unknown. Phosphorylated by CDK1. There are 8 Ser/Thr phosphorylation sites. Among them, Ser-1126 phosphorylation is the major site, which conducts to the enzyme inactivation. |
| 相似性 | Belongs to the peptidase C50 family. |
| 功能 | Caspase-like protease, which plays a central role in the chromosome segregation by cleaving the SCC1/RAD21 subunit of the cohesin complex at the onset of anaphase. During most of the cell cycle, it is inactivated by different mechanisms. |
| 保存条件 | Shipped at 4℃. Store at -20℃ for one year. Avoid repeated freeze/thaw cycles. |
| 注意事项 | This product as supplied is intended for research use only, not for use in human, therapeutic or diagnostic applications. |
| 背景资料 | Separase is a cysteine protease that is essential for mitotic progression by separating sister chromatids. Each cell must receive one chromatid of every chromosome, during mitosis. Cohesin plays an important role in cohering sister chromatids during the prophase through anaphase stages of mitosis, making certain that genomic information is replicated accurately. As the cellular division process continues, separase destroys cohesin by means of cleavage, allowing the chromatids to separate and divide with the cell. Separase activity is highly regulated. It not only cleaves cohesin at the onset of anaphase but also cleaves itself, promoting downregulation of separase after anaphase. Should a human cell become an aneuploid (one too many or too few chromatids), the embryo most likely will not survive. Should the embryo survive, it will most likely develop severe birth defects or later develop malignant cancers. |
| 应用 | 推荐稀释比例 |
| {IHC-P} | {1:100-500} |
| {IHC-F} | {1:100-500} |
| {IF} | {1:100-500} |
风险提示:丁香通仅作为第三方平台,为商家信息发布提供平台空间。用户咨询产品时请注意保护个人信息及财产安全,合理判断,谨慎选购商品,商家和用户对交易行为负责。对于医疗器械类产品,请先查证核实企业经营资质和医疗器械产品注册证情况。
 文献和实验
文献和实验:使用 Anti-phospho-Akt (Ser473) Rabbit mAb 对石蜡包埋的人乳腺癌组织进行免疫组织化学分析。(图 A)使用免疫组化试剂盒M&R HRP/DAB Detection IHC Kit,抗体 1:100 稀释;(图 B) 采用普通免疫组化试剂盒,抗体 1:25 稀释。 图 6 免疫组化实验检测 Erk1/2 表达 注:使用 Anti-Erk1/2 Mouse mAb与p44/42 MAPK (Erk1/2)Rabbit mAb 对正常小鼠心脏组织进行免疫
at 10, 25, and 50 μM). At 24 h post-treatment, celllysates were obtained; SDS-PAGE and Western blotting were performed as described in Section 3, Methods. AR-A014418dose-dependent decreases of phospho-β-catenin (Ser33/37) and phospho-glycogen synthase
(Ser473)(193H12)Rabbit mAb,1:300,稀释,二抗是驴抗兔,1:2000,我是实验室的新手,刚呆俩月,受 此挫折,一头雾水,请过来人或者有经验的同学帮忙解答怎样解决,非常感谢! 碧峤 pAkt有两个位点,Ser473和Thr308,其中Ser473相对容易显色。如果显色失败,可能的原因:1 上样量过少,我们一般都是30μg;2 一抗孵育时间过短,我们一般24h~48h;3 一抗是否工作有待排除 米宝
 技术资料
技术资料暂无技术资料 索取技术资料





